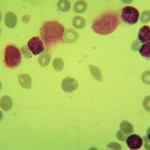
Foto da extensão sanguínea 2
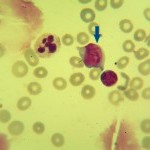
Foto da extensão sanguínea 3
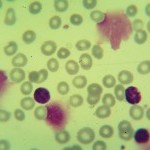
Foto da extensão sanguínea 5

Caso nº 4
Caso Clínico #6
Local: Curitiba-PR
Mês / Ano: Abril/2003
Assuntos relacionados: Leucemia linfocítica crônica. Adulto. Sexo Masculino.
Quadro Clínico
Paciente do sexo masculino, 67 anos.
O aparelho liberou os seguintes alarmes: hipocromia, anisocitose, linfócitos atípicos?, blastos?.
Com base nos dados clínicos e laboratoriais, propomos as seguintes questões para discussão do caso:
Com base nos alarmes do equipamento, resultado do hemograma e nas fotos da extensão sanguínea indique a hipótese diagnóstica laboratorial e faça uma breve discussão sobre sua escolha.
Referências Bibliográficas
SILVA, Paulo Henrique, et al. Hematologia Laboratorial: teoria e procedimentos. Porto Alegre, Ed. Artmed, 2016.
Dados Laboratoriais
-
Eritrócitos
3.450.000/uL
Hemoglobina
9,0 g/dL
Volume globular
29,1%
VCM
84,4 fL
HCM
26,2%
CHCM
31,5%
RDW
17,5%
Leucócitos
293.450/uL
Plaquetas
353.000%
Basófilos
4,8%
Linfócitos
96,4%
Monócitos
0,3%
Neutrófilos
3,2%
Respostas da discussão
Hipótese diagnóstica laboratorial
Leucemia linfocítica crônica.
Discussão do caso laboratorial
Este é um caso de leucemia linfocítica crônica (LLC). O que faz pensar que seja uma LLC é o número de linfócitos, que apresenta valor relativo de 282.886/µL, bem como a associação do número de linfócitos com a idade do paciente (67 anos). Sempre que houver uma linfocitose acima de 5.000/µL em pacientes com idade superior aos 40 anos deve-se pensar em LLC. O National Cancer Institute recomenda os seguintes critérios para o diagnóstico da LLC clássica:
- contagem de linfócitos em sangue periférico (hemograma) acima de 5.000 linfócitos/microlitro. As células com morfologia atípica não devem estar acima de 55%, as células devem ser CD5+ e apresentar marcadores como CD19+, CD20+, CD23+ e baixa densidade de imunoglobulinas de superfície.
- mielograma com mais de 30% de linfócitos (medula óssea).
Os critérios devem ser seguidos para que se possa fazer o diagnóstico definitivo da LLC e o diagnóstico diferencial de outras causas de linfocitose.
A tabela a seguir mostra a classificação das LLC.
|
TIPOS DE LLC |
PRINCIPAIS CARACTERÍSTICAS MORFOLÓGICAS |
|
LLC COMUM OU CLÁSSICA |
PREDOMÍNIO DE LINFÓCITOS MADUROS E PEQUENOS |
|
LLC MISTA |
PROPORÇÃO VARIÁVEL DE LINFÓCITOS ATÍPICOS. MENOS DE 10% DE PRÓLINFÓCITOS |
|
LLC EM TRANSFORMAÇÃO PRÓLINFOCÍTICA |
O NÚMERO DE PRÓLINFÓCITOS FICA ACIMA DE 10% E ABAIXO DE 55% |
|
LLC PRÓLINFOCÍTICA |
PRÓLINFÓCITOS ACIMA DE 55% |
Em torno de 80% das LLC correspondem a forma clássica. Na foto da extensão sanguínea 3 há uma célula apontada por uma seta, esta célula é um prólinfócito. No hemograma, além da contagem de linfócitos (sempre valorizar o valor absoluto e não o relativo) deve-se ter atenção à morfologia dos linfócitos. A partir da suspeita, pelo hemograma, de uma LLC deve-se fazer a imunofenotipagem. Ela ao detectar um clone de linfócitos CD5+ e outros marcadores faz o diagnóstico da LLC. A imunofenotipagem é importante para diferenciar a LLC de outras doenças que cursam com linfocitose. O quadro a seguir reforça os critérios para o diagnóstico definitivo da LLC. Ainda em relação a morfologia, uma característica da LLC é a presença de restos celulares que se fazem presentes em quase todas as fotos. Muitas vezes estes restos celulares são chamados de sombras de Grumpecht. Atualmente, são uma característica morfológica da LLC e não tem um significado clínico.
A LLC é uma doença característica de idosos. Mais de 90% dos pacientes tem uma idade acima de 50 anos e em torno de 65% dos pacientes tem idade superior a 65 anos. Em 99% dos casos a célula transformada é um linfócito B que prolifera e acumula no sangue periférico, linfonodos e outros órgãos. Os linfócitos transformados não respondem a estímulos antigênicos. Eventualmente a célula transformada pode ser um linfócito T.